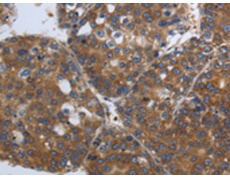
一抗

|
Background: |
This gene encodes a member of the STAT-induced STAT inhibitor (SSI), also known as suppressor of cytokine signaling (SOCS), family. SSI family members are cytokine-inducible negative regulators of cytokine signaling. The expression of this gene can be induced by a subset of cytokines, including IL2, IL3 erythropoietin (EPO), CSF2/GM-CSF, and interferon (IFN)-gamma. The protein encoded by this gene functions downstream of cytokine receptors, and takes part in a negative feedback loop to attenuate cytokine signaling. Knockout studies in mice suggested the role of this gene as a modulator of IFN-gamma action, which is required for normal postnatal growth and survival. |
|
Applications: |
ELISA, WB, IHC |
|
Name of antibody: |
SOCS1 |
|
Immunogen: |
Synthetic peptide of human SOCS1 |
|
Full name: |
Suppressor of cytokine signaling 1 |
|
Synonyms: |
JAB, CIS1, SSI1, TIP3, CISH1, SSI-1, SOCS-1 |
|
SwissProt: |
O15524 |
|
ELISA Recommended dilution: |
2000-10000 |
|
IHC positive control: |
Human liver cancer and Human ovarian cancer |
|
IHC Recommend dilution: |
100-300 |
|
WB Predicted band size: |
24 kDa |
|
WB Positive control: |
HT-29 and 231 cells |
|
WB Recommended dilution: |
500-2000 |


 購物車
購物車 幫助
幫助
 021-54845833/15800441009
021-54845833/15800441009